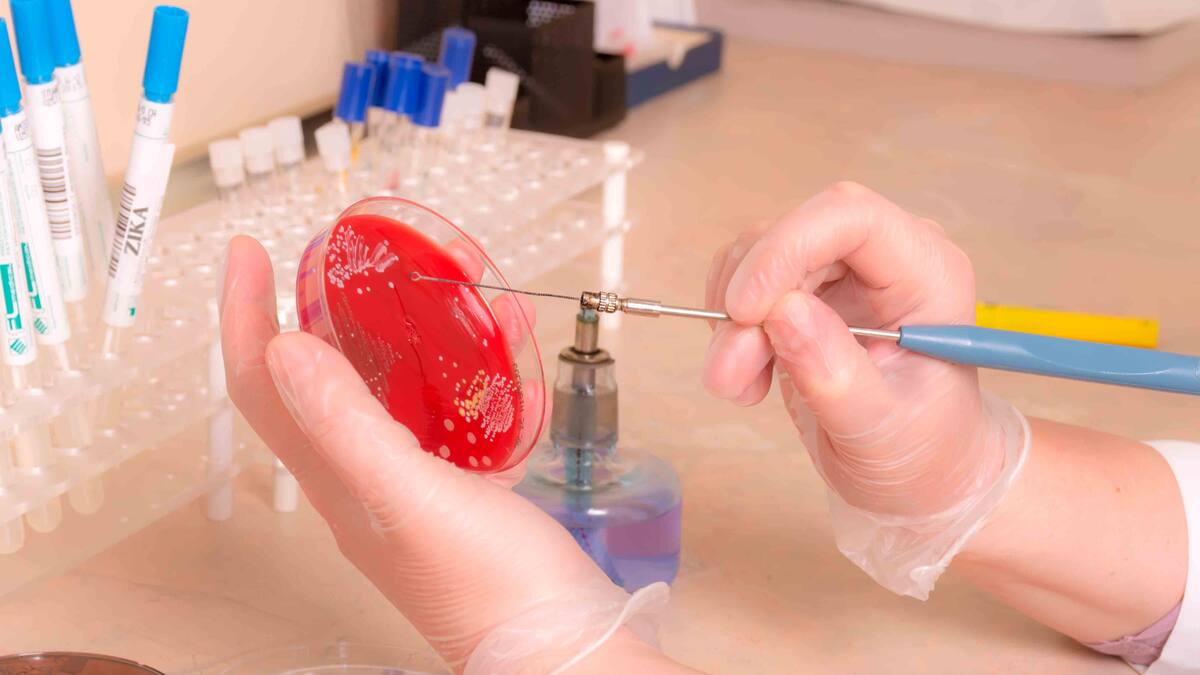

Algunos cálculos preliminares muestran que durante la fase inicial de esta epidemia podríamos llegar a tener más de 2000 recién nacidos con microcefalia (sabemos que la severidad de la misma puede variar dentro de un gran espectro) en los países con transmisión del virus. Los casos de microcefalia tienen una expectativa de vida variable, pero de manera general se calcula en alrededor de los 25 años; los datos anteriores permiten calcular que en un muy corto periodo de tiempo entrarían como carga de enfermedad 50.000 años de discapacidad.
Los costos directos que corresponden a la atención en salud necesarios en la etapa aguda, a la atención a largo plazo y a la asistencia institucional y educación especial, podrían estar en alrededor de US 12.000 por año por cada paciente.
El impacto económico puede llegar a ser tan severo que recientemente el Banco Mundial dijo que la epidemia del virus zika costará este año a Latinoamérica y el Caribe casi 4000 millones de dólares, entre pérdidas de ingresos y el impacto fiscal, un 0,07% del Producto Interior Bruto de la región. De confirmarse la transmisión sexual del virus y su asociación con el síndrome de Guillain-Barré, 'el efecto podría ser mucho mayor y necesitará ser valorado de nuevo', dijo Jim Yong Kim, presidente del Banco Mundial.
En neonatología y pediatría durante muchos años hemos convivido con los efectos teratogénicos de las infecciones intrauterinas. Sin que se hiciese muy evidente, durante la reciente epidemia de chikunguña se diagnosticaron más de 200 recién nacidos con la enfermedad en Colombia con la gran complicación de que uno de cada dos de los afectados puede quedar con algún grado de parálisis cerebral, por el tropismo por sistema nervioso central que tiene este virus.
Los efectos de estas infecciones en la población de recién nacidos en América Latina y el Caribe, se ve magnificada por las cifras que muestran que un tercio de las mujeres que no quieren quedar embarazadas no utiliza ningún tipo de método anticonceptivo. Esta realidad afecta con mayor impacto a las adolescentes de la región, población que cada año producen 1,2 millones de embarazos no deseados, llevando esto a la conclusión de que el 18% de todos los nacimientos se dan en madres de entre los 15 y 19 años, según la Organización Panamericana de la Salud (OPS).
Con este oscuro panorama que evidencia la ausencia de políticas públicas efectivas específicas para adolescentes y jóvenes en muchos de nuestros países, unidas a una muy escasa educación sexual, hace que la medida implementada con la recomendación de la postergación de embarazos, se presiente que tenga menos impacto del previsto.